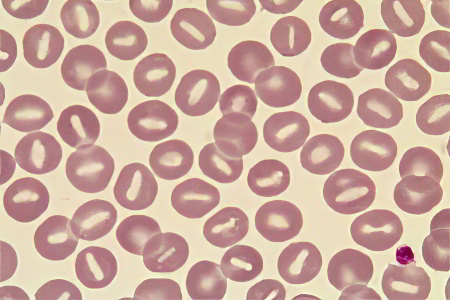
Простая гиперволемия Простая гиперволемия

Причины и виды гиперволемии
Гиперволемия не является отдельным заболеванием, а представляет собой совокупность симптомов, связанных с различными патологиями.
В крови выделяют два основных компонента:
- жидкую часть — плазму;
- форменные элементы — клетки крови.
Гематокрит — это соотношение объема клеток крови к общему объему крови в сосудистой системе. Нормальные значения гематокрита колеблются от 36 до 48%. Это означает, что в 100 мл крови содержится 36-48 мл клеток, а оставшиеся 52-64 мл составляют плазму. Классификация заболевания зависит от уровня гематокрита.
Гиперволемия, или избыток жидкости в организме, вызывает серьезные опасения у врачей. Это состояние может привести к отекам, повышению артериального давления и даже сердечной недостаточности. Врачи отмечают, что гиперволемия часто возникает при заболеваниях почек, сердца или печени, а также может быть следствием избыточного потребления соли и жидкости. Лечение гиперволемии включает в себя коррекцию диеты, ограничение потребления натрия и жидкости, а также применение диуретиков для выведения лишней жидкости. Важно, чтобы пациенты проходили регулярные обследования и следовали рекомендациям специалистов, чтобы избежать осложнений и улучшить качество жизни. Врачи подчеркивают, что индивидуальный подход к каждому пациенту является ключевым в успешном лечении этого состояния.

Простая гиперволемия
При данной патологии уровень гематокрита остается в норме, однако увеличивается объем циркулирующей крови.
Причины:
- Переливание объема крови, превышающего возможности сосудистой системы;
- Интенсивные физические нагрузки;
- Существенное повышение температуры окружающей среды;
- Гипоксия.
Во всех перечисленных случаях, кроме первого, кровь поступает в кровеносную систему из внутренних резервов организма.
| Симптом | Возможная причина гиперволемии | Лечение |
|---|---|---|
| Одышка | Застойная сердечная недостаточность | Диуретики (например, фуросемид), ограничение потребления жидкости и соли |
| Отеки (опухание ног, лодыжек, рук) | Почечная недостаточность | Диализ, диуретики, ограничение потребления жидкости и соли |
| Увеличение веса | Переливание крови | Ограничение жидкости, коррекция основного заболевания |
| Повышенное артериальное давление | Цирроз печени | Лечение основного заболевания, диуретики |
| Тахикардия (учащенное сердцебиение) | Синдром Кушинга | Лечение основного заболевания, диуретики |
| Увеличение центрального венозного давления | Недостаточность правого желудочка | Лечение основного заболевания, диуретики, инотропные препараты |
| Припухлость шеи | Тромбоз глубоких вен | Лечение основного заболевания, диуретики, тромболитики (в некоторых случаях) |
Олигоцитемическая гиперволемия
Показатель гематокрита снижается ниже норм, что приводит к увеличению объёма крови за счёт роста объёма плазмы. Это, в свою очередь, вызывает гидремию.
Причины, способствующие развитию гидремии:
- Беременность — изменения в составе крови обеспечивают эффективный обмен веществ между плодом и организмом матери.
- Активный приток жидкости в сосудистую систему: переливание плазмы и её заменителей, проникновение жидкости из окружающих тканей при отёках через стенки сосудов, чрезмерное потребление жидкости.
- Сбой в процессе дегидратации: задержка натрия, почечная недостаточность, повышенная выработка антидиуретического гормона.
Гиперволемия — это состояние, при котором в организме наблюдается избыточное количество жидкости. Люди, сталкивающиеся с этой проблемой, часто описывают симптомы, такие как отеки, одышка и повышенное артериальное давление. Многие связывают гиперволемию с заболеваниями сердца и почек, что подчеркивает важность своевременной диагностики. Лечение обычно включает ограничение потребления соли и жидкости, а также применение диуретиков для выведения излишков жидкости. Важно помнить, что самолечение может быть опасным, поэтому консультация с врачом необходима для определения причины и выбора правильной терапии. Понимание своего состояния и соблюдение рекомендаций специалистов помогут избежать серьезных осложнений.

Полицитемическая гиперволемия
В данном случае гиперволемия проявляется повышением уровня гематокрита, что связано с увеличением доли клеточных элементов в крови.
Причины:
- гематологические заболевания: опухоли различного происхождения, генетические аномалии;
- гипоксия, возникающая при длительном пребывании на высоких высотах, а также при сердечной и легочной недостаточности.
Симптомы, диагностика и лечение гиперволемии
От типа заболевания зависят его проявления и подходы к лечению. Если недуг вызван факторами, к которым организм способен адаптироваться, и его симптомы временные, система кровообращения может восстановиться самостоятельно.
Когда болезнь связана с острыми или хроническими нарушениями работы органов и систем, терапия сосредоточена на снижении объема циркулирующей крови и коррекции симптомов.
Симптомы:
- Повышенное артериальное давление;
- Проявления стенокардии и сердечной недостаточности;
- Одышка;
- Отечность;
- Чувство тяжести при дыхании и учащение дыхания;
- Боль в поясничной области;
- Головные боли;
- Увеличение веса;
- Проблемы с мочеиспусканием;
- Сухость кожи и слизистых;
- Повышенная утомляемость.
Современная медицина не располагает методами для точного определения объема циркулирующей крови. Текущие диагностические подходы применяются только в научных исследованиях и не имеют практического применения. Для выявления типа заболевания и его причин в гематологии используется показатель гематокрита.
Лечение заболевания осуществляется в двух основных направлениях:
- Этиотропное лечение – направлено на устранение причины гиперволемии;
- Симптоматическое лечение – нацелено на облегчение проявлений заболевания.
Цели этиотропного лечения:
- Хирургическое вмешательство при пороках сердца;
- Лечение заболеваний эндокринной и мочевыделительной систем;
- Генетически обусловленные расстройства кровеносной системы;
- Опухоли различной природы;
- Контроль объема инфузий при внутривенных вливаниях.
Направления симптоматического лечения:
- Снижение повышенного артериального давления с помощью гипотензивных средств в сочетании с диуретиками;
- Уменьшение нагрузки на сердце с использованием препаратов для лечения стенокардии;
- Обеспечение пациента комфортной температурой и кислородом.
Рецепты народной медицины:
- Гирудотерапия (лечение пиявками): способствует уменьшению объема крови, разжижает ее и немного снижает количество форменных элементов;
- Растительные диуретики: фенхель, хвощ, толокнянка, укроп, калина.
Крайне важно, чтобы все диагностические и лечебные процедуры проводились под контролем квалифицированного врача, так как на первый взгляд безобидное состояние может скрывать начальные стадии серьезного заболевания.

Гиперволемия малого круга кровообращения
Кровеносная система человека делится на два основных круга: большой и малый. Большой круг включает сосуды, которые обеспечивают кровоснабжение всех органов и тканей, кроме тех, что обслуживают бронхо-лёгочную систему. Малый круг состоит исключительно из сосудов, связанных с лёгкими.
Распределение крови в системе кровообращения выглядит следующим образом:
- в венах – 70%;
- в артериях – 15%;
- в капиллярах – 12%;
- в сердечной мышце – 3%.
В большом круге кровообращения находится 75-80% общего объёма крови, тогда как в малом круге – 20-25%.
Гиперволемия в малом круге кровообращения возникает из-за повышенного давления в сосудах бронхо-лёгочной системы, что и обуславливает термин «лёгочная гипертензия».
Причины гиперволемии малого круга
Факторы, способствующие развитию лёгочной гипертензии:
- Рефлекторное сужение мелких сосудов лёгких. Это состояние может возникнуть при сильном стрессе, стенозе митрального клапана или эмболии.
- Длительная альвеолярная гипоксия, вызванная заболеваниями, такими как силикоз, хронический бронхит, эмфизема, обструктивная болезнь лёгких, антракноз, бронхиолит и бронхоэктаз.
- Недостаточность левого желудочка, часто связанная с сердечными аритмиями, инфарктом или миокардитом.
- Увеличение вязкости крови.
- Повышение давления в дыхательных путях, что может происходить при сильном кашле, повышении атмосферного давления или нарушениях в проведении искусственной вентиляции лёгких.
- Сужение сосудов, отвечающих за отток крови из лёгких. Причинами могут быть аневризмы аорты, опухоли, спайки или врождённые пороки развития.
- Генетически обусловленные нарушения в ферментной системе.
- Увеличение объёма крови, выбрасываемого правым желудочком.
- Наркотическая интоксикация психостимуляторами.
- Инфекция вирусом СПИДа.
- Портальная гипертензия, вызванная циррозом печени или синдромом Бадда-Киари.
- Апноэ — остановка дыхания во время сна, часто сопровождающаяся храпом.
Кроме перечисленных факторов, существуют также идиопатические (неизвестные) причины, которые могут приводить к первичной лёгочной гипертензии.
Признаки гиперволемии лёгких
На начальной стадии заболевания пациент может не замечать его проявлений. Однако, когда симптомы становятся очевидными и указывают на серьезные изменения, болезнь, как правило, уже находится в запущенной форме, и восстановление становится невозможным.
Основные признаки патологии включают:
- одышку, которая может перерасти в удушье при физической активности;
- астению, проявляющуюся бессонницей, потерей веса, снижением работоспособности и нестабильным психоэмоциональным состоянием;
- обмороки во время физической нагрузки;
- головокружение;
- интенсивный кашель без выделения мокроты, в тяжелых случаях с примесью крови;
- боли в области сердца;
- нарастающий цианоз;
- аритмию;
- дискомфорт в области печени.
Диагностика гиперволемии малого круга
Диагностика заболевания основывается на клинических проявлениях, а также на результатах лабораторных и инструментальных исследований:
- Электрокардиограмма (ЭКГ) – позволяет выявить гипертрофию правого желудочка, инфаркт, нарушения ритма сердца и тромбоэмболию лёгочной артерии.
- Рентгенография грудной клетки – на поздних стадиях заболевания помогает обнаружить усиление сосудистого рисунка и гипертрофию различных отделов сердечной мышцы.
- Компьютерная томография с контрастированием – предоставляет важную информацию о состоянии сердца и сосудов.
- Ультразвуковое исследование сердца – используется для диагностики врождённых аномалий, гипертрофии сердечной мышцы и уточнения параметров сосудистого кровотока.
- Катетеризация лёгочного ствола с установкой датчика – позволяет измерить давление в системе малого круга кровообращения и выявить или исключить наличие патологии.
Лечение лёгочной гиперволемии
Основное направление лечения данной патологии — устранение её первопричины, так как гиперволемия не является отдельным заболеванием. Лёгочную гиперволемию могут вызывать патологические процессы в различных системах организма. Наиболее сложной в лечении является первичная гипертензия, поскольку её причина остаётся неясной, и источник негативных симптомов не установлен.
В терапии лёгочной гиперволемии применяются медикаменты и методы, используемые в стандартных протоколах лечения артериальной гипертензии. Если гипотензивная терапия оказывается неэффективной, могут быть назначены Эуфиллин и кислородотерапия.
Вопрос-ответ
Что такое гиперволемия простыми словами?
Гиперволемия — увеличение объёма циркулирующей крови и плазмы. В норме средние значения объёма циркулирующей крови и объёма циркулирующей плазмы у мужчин составляют соответственно 69 и 39 мл/кг массы тела, у женщин — 65 и 40 мл/кг массы тела. Все причины, вызывающие гипергидратацию, приводят к развитию гиперволемии.
Что такое простая гиперволемия?
Нормоцитемическая или простая гиперволемия обычно связана с переливанием значительных объемов крови, состояниями кислородного голодания (гипоксии) с высвобождением всех запасов крови в организме, физическими перегрузками. Гематокритное число при этом, как правило, соответствует норме.
Что увеличивает объем крови в организме?
Правильное питание: рацион, богатый фруктами, овощами, цельными зернами и здоровыми жирами, способствует улучшению сосудистого здоровья. Гидратация: достаточное потребление воды поддерживает объем крови и улучшает циркуляцию.
Советы
СОВЕТ №1
Обратитесь к врачу при первых симптомах гиперволемии, таким как отеки, одышка или повышение артериального давления. Ранняя диагностика поможет избежать серьезных осложнений и позволит начать лечение на ранней стадии.
СОВЕТ №2
Следите за своим уровнем потребления соли и жидкости. Ограничение соли может помочь снизить задержку жидкости в организме, что важно для контроля гиперволемии. Обсудите с врачом оптимальный уровень потребления для вашего случая.
СОВЕТ №3
Регулярно проводите мониторинг веса и объема жидкости, особенно если вы находитесь в группе риска. Ведение дневника поможет вам отслеживать изменения и своевременно реагировать на них.
СОВЕТ №4
Следуйте рекомендациям врача по медикаментозному лечению и не прерывайте курс без консультации. Некоторые препараты, такие как диуретики, могут быть необходимы для контроля уровня жидкости в организме.